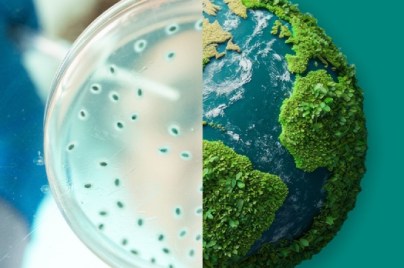

Philanthropy
Philanthropy is critical to helping us fulfill our company’s commitment to improving access to health around the globe. We’re working to support sustainable solutions to key global health challenges and to strengthen communities where our employees live and work.
We strive to improve the health and well-being of people around the world
We envision a world where all people have access to the high-quality health care they need and deserve. That’s why we’re working tirelessly to reduce health disparities for people through our philanthropic programs and partnerships.
Our philanthropic approach
We provide financial and product donations while also supporting our communities through employee volunteer programs and charitable grants to local nonprofits addressing critical health and social needs.
Guiding principles
Our guiding principles shape our program investments and partnerships. Our key principles are:
- Addressing global health needs where we can have a substantial impact.
- Addressing health disparities in underserved communities.
- Collaborating with diverse partners to build healthier, stronger communities.
- Leveraging our resources — financial, product and expertise — to achieve greater positive impact on health outcomes.
Philanthropic priorities
Our philanthropic programs prioritize areas of global health need where we can use our expertise to make a difference. We also focus on strengthening communities around the world where we operate. We’re prioritizing:
- Reducing health disparities among people living with cancer, cardiovascular disease, diabetes and HIV/AIDS in underserved communities.
- Strengthening health systems to improve the delivery of high-quality care.
- Empowering patients to better manage their health by helping them overcome social and environmental barriers to care.
- Supporting local nonprofit organizations in our communities and sharing employees’ expertise through volunteerism.
Grant guidelines and submission process
Our grant guidelines provide information about the proposal content elements and submission process. Please note that Social Impact and Sustainability and our company’s Foundation do not accept unsolicited proposals.
- Familiarize yourself with our grant application guidelines, including eligibility criteria and proposal requirements.
- Submit your grant proposal through the online grants management system.
- View our company’s charitable contributions and the Foundation’s grants on our website.
Our commitment in action

Improving health care access
We work with a range of stakeholders, including multilateral agencies, non-governmental organizations and governments to strengthen health systems, doing our part to ensure care is high-quality, culturally responsive and equitable.

Strengthening our communities
We aspire to have a positive impact on communities around the world. Our community engagement programs aim to build stronger communities by helping address critical health and social needs.

Global emergency response
We’re committed to supporting communities around the world that are affected by natural disasters and humanitarian crises.

Product donation programs
We don’t just develop new medicines and vaccines, we work hard to help get them to the people who need them. We donate our medicines and vaccines to address specific health needs in communities with limited access to health care and in humanitarian crises.

Our employees give back
Our employees are passionate about giving back to their communities. Each year, our employees donate thousands of hours and millions of dollars to nonprofit organizations to help improve the health and well-being of communities around the world.
MSD Foundation
Our company’s Foundation is a private charitable organization established and funded by the company. It’s a separate legal entity from the company and operates independently.